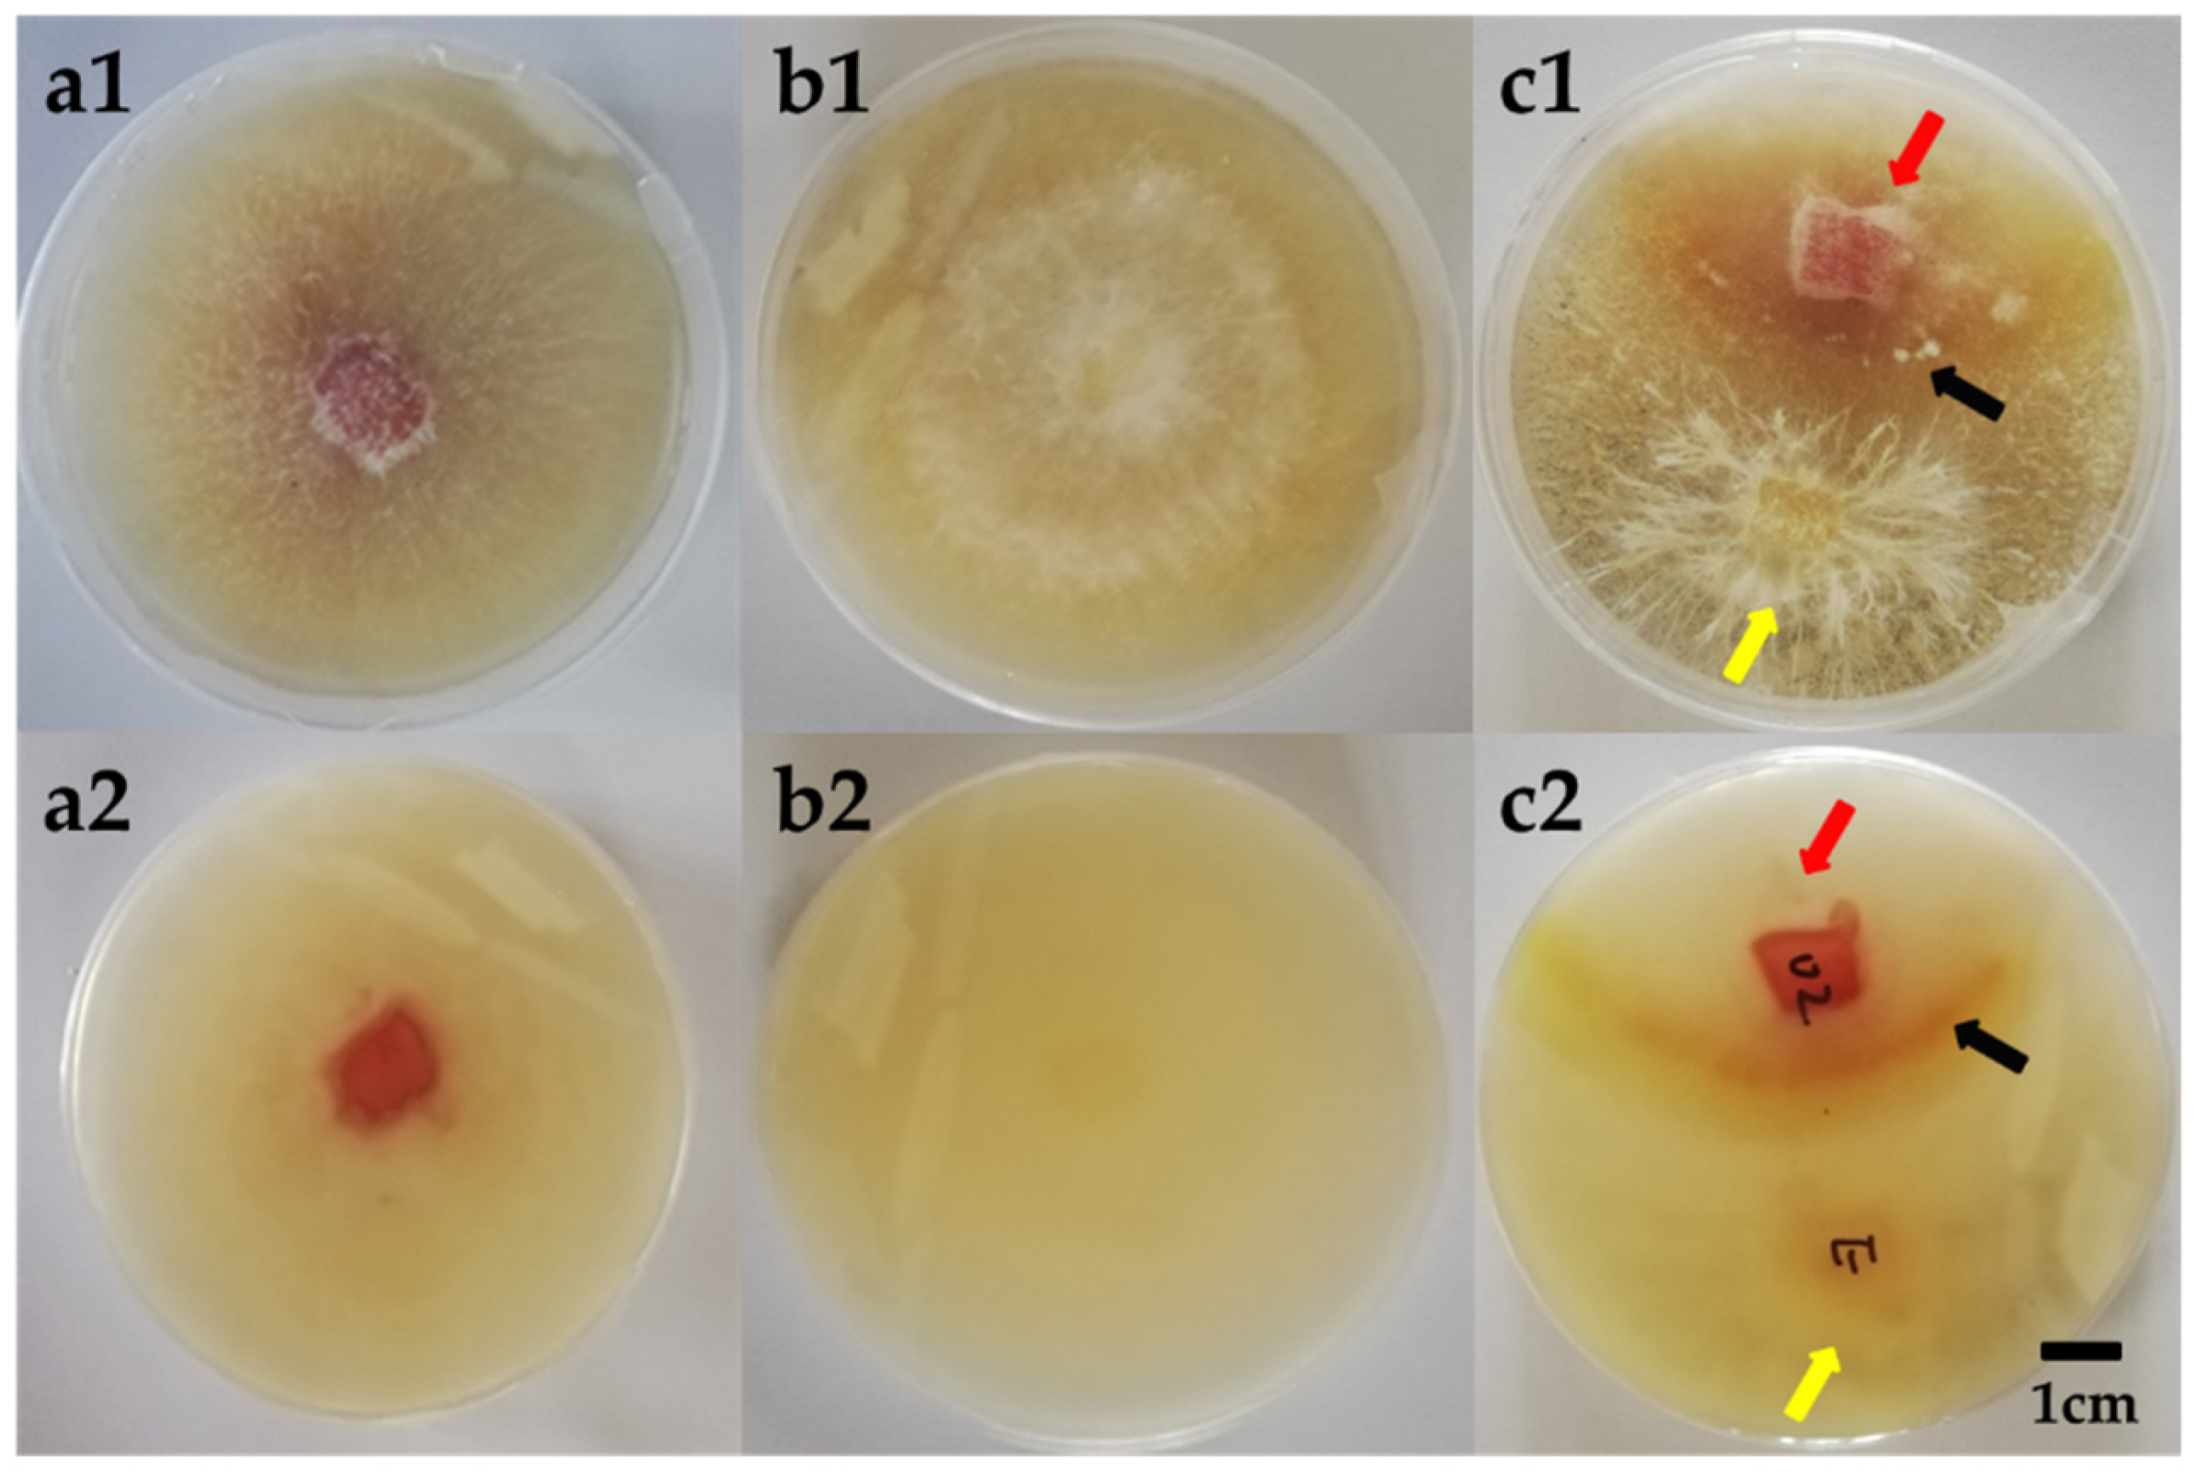
Fermentation 07 00316 g003

Promotion of the Hypocrellin Yield by a Co-Culture of Shiraia bambusicola (GDMCC 60438) with Arthrinium sp. AF-5 Fungus
Abstract
:1. Introduction
2. Materials and Methods
2.1. Preparation of the Endophytic Fungi Inculumn for Co-Culture
2.2. HA Fermentation by Co-Culture of S. bambusicola and Endophytic Fungi
2.3. Strain Identification
2.4. The Effect of Cultivition Conditions on the HA Yields with the S. bambusicola (GDMCC 60438) and the AF-5 Strain
2.5. Morphological Observation of the Mycellium Pellets from the Co-Culture
2.6. Analytical Assays
2.7. Statistical Analysis
3. Results and Discussion
3.1. The HA Yields by Co-Culture of S. bambusicola (GDMCC 60438) with Different Endophytic Fungi
3.2. Molecular Identification and the Culture Features of the Endophytic AF-5 Strain with the S. bambusicola (GDMCC 60438)
3.3. Effect of Different Types of the AF-5 Inoculums on the HA Yields
3.4. Effect of Introducing Time of the AF-5 Strain on the HA Yield
3.5. Effect of Dosage of the AF-5 Strain on the HA Yield
3.6. Effect of the Co-Culture Time on the HA Yield
3.7. Morphological Observation of the Mycelium Pellets during the Co-Culture
3.8. Effect of the H2O2 Addtives on the HA Yield during the Co-Culture
4. Conclusions
Author Contributions
Funding
Institutional Review Board Statement
Informed Consent Statement
Data Availability Statement
Conflicts of Interest
References
- Ali, S.M.; Olivo, M. Efficacy of Hypocrellins Pharmacokinetics in Phototherapy. Int. J. Oncol. 2003, 21, 1229–1237. [Google Scholar] [CrossRef]
- Cheng, T.F.; Jia, X.M.; Ma, X.H.; Lin, H.P.; Zhao, Y.H. Phylogenetic Study on Shiraia Bambusicola by Rdna Sequence Analyses. J. Basic Microbiol. 2010, 44, 339–350. [Google Scholar] [CrossRef] [PubMed]
- Doungporn, M.; Hiroko, K.; Tatsuji, S. Molecular Diversity of Bamboo-Associated Fungi Isolated from Japan. FEMS Microbiol. Lett. 2010, 1, 10–19. [Google Scholar]
- Jia, X.M.; Xu, X.H.; Zhuang, B.C.; Lin, H.P. The Progress of Biological Research of Medicinal Fungus Shiraia Bambusicola. Microbiology 2006, 33, 147–150. [Google Scholar]
- Ca, I.Y.; Ding, Y.; Tao, G.; Liao, X. Production of 1,5-Dihydroxy-3-Methoxy-7-Methylanthracene-9,10-Dione by Submerged Culture of Shiraia Bambusicola. J. Microbiol. Biotechnol. 2008, 18, 322. [Google Scholar]
- Kishi, T.; Tahara, S.; Taniguchi, N.; Tsuda, M.; Takahashi, S. New Perylenequinones from Shiraia Bambusicola. Planta Med. 1991, 57, 376–379. [Google Scholar] [CrossRef]
- Cai, Y.; Wei, Z.; Liao, X.; Ding, Y.; Sun, J. Characterization of Three Extracellular Polysaccharides from Shiraia sp. Super-H168 under Submerged Fermentation. Carbohydr. Polym. 2010, 82, 34–38. [Google Scholar] [CrossRef]
- Ali, S.M.; Chee, S.K.; Yik, G. Hypericin and Hypocrellins Induced Apoptosis in Human Mucosal Carcinoma Cells. J. Photochem. Photobiol. B Biol. 2001, 65, 59–73. [Google Scholar] [CrossRef]
- Wang, N.; Zhang, Z. Relationship between Photosensitizing Activities and Chemical Structure of Hypocrellins a and B. J. Photochem. Photobiol. B 1992, 14, 207–217. [Google Scholar]
- Chaloupka, R.; Sureau, F.; Kocisova, E.; Petrich, J.W. Hypocrellins a Photosensitization Involves an Intracellular Ph Decrease in 3t3 Cells. Photochem. Photobiol. 2010, 68, 44–50. [Google Scholar] [CrossRef]
- Hudson, J.; Zhou, J.; Chen, J.; Harris, L.; Yip, L.; Towers, G. Hypocrellins, from Hypocrella Bambuase, Is Phototoxic to Human Immunodeficiency Virus. Photochem. Photobiol. 2010, 60, 253–255. [Google Scholar] [CrossRef] [PubMed]
- Zhenjun, D.; Lown, J.W. Hypocrellins and Their Use in Photosensitization. Photochem. Photobiol. 1990, 52, 609–616. [Google Scholar] [CrossRef] [PubMed]
- Yang, H.; Xiao, C.; Ma, W.; He, G. The Production of Hypocrellins Colorants by Submerged Cultivation of the Medicinal Fungus Shiraia Bambusicola. Dye. Pigment. 2009, 82, 142–146. [Google Scholar] [CrossRef]
- Lei, X.Y.; Zhang, M.Y.; Ma, Y.J.; Wang, J.W. Transcriptomic Responses Involved in Enhanced Production of Hypocrellins a by Addition of Triton X-100 in Submerged Cultures of Shiraia Bambusicola. J. Ind. Microbiol. Biotechnol. 2017, 44, 1425–1429. [Google Scholar] [CrossRef] [PubMed]
- Deng, H.; Liang, W.; Fan, T.P.; Zheng, X.; Cai, Y. Modular Engineering of Shiraia Bambusicola for Hypocrellins Production through an Efficient Crispr System. Int. J. Biol. Macromol. 2020, 165, 796–803. [Google Scholar] [CrossRef]
- Bertrand, S.; Bohni, N.; Schnee, S.; Schumpp, O.; Gindro, K.; Wolfender, J.L. Metabolite Induction Via Microorganism Co-Culture: A Potential Way to Enhance Chemical Diversity for Drug Discovery. Biotechnol. Adv. 2014, 32, 1180–1204. [Google Scholar] [CrossRef]
- Bérdy, J. Thoughts and Facts About Antibiotics: Where We Are Now and Where We Are Heading. J. Antibiot. 2012, 65, 385–395. [Google Scholar] [CrossRef] [Green Version]
- Brakhage, A.A. Regulation of Fungal Secondary Metabolism. Nat. Rev. Microbiol. 2013, 11, 21–32. [Google Scholar] [CrossRef]
- Keller, N.P.; Turner, G.; Bennett, J.W. Fungal Secondary Metabolism-from Biochemistry to Genomics. Nat. Rev. Microbiol. 2005, 3, 937–947. [Google Scholar] [CrossRef]
- Boruta, T.; Milczarek, I.; Bizukojc, M. Evaluating the Outcomes of Submerged Co-Cultivation: Production of Lovastatin and Other Secondary Metabolites by Aspergillus Terreus in Fungal Co-Cultures. Appl. Microbiol. Biotechnol. 2019, 103, 5593–5605. [Google Scholar] [CrossRef] [Green Version]
- Bader, J.; Mast-Gerlach, E.; Popovi, M.K.; Bajpai, R.; Stahl, U. Relevance of Microbial Coculture Fermentations in Biotechnology. J. Appl. Microbiol. 2010, 109, 371–387. [Google Scholar] [CrossRef] [PubMed]
- Smid, E.; Lacroix, C. Microbe–Microbe Interactions in Mixed Culture Food Fermentations. Curr. Opin. Biotechnol. 2013, 24, 148–154. [Google Scholar] [CrossRef] [PubMed]
- Scherlach, K.; Hertweck, C. Triggering Cryptic Natural Product Biosynthesis in Microorganisms. Org. Biomol. Chem. 2009, 7, 1753–1760. [Google Scholar] [CrossRef] [PubMed]
- Chagas, F.O.; Dias, L.G.; Pupo, M.T. A Mixed Culture of Endophytic Fungi Increases Production of Antifungal Polyketides. J. Chem. Ecol. 2013, 39, 1335–1342. [Google Scholar] [CrossRef]
- Marmann, A.; Aly, A.; Lin, W.; Wang, B.; Proksch, P. Co-Cultivation—a Powerful Emerging Tool for Enhancing the Chemical Diversity of Microorganisms. Mar. Drugs 2014, 12, 1043–1065. [Google Scholar] [CrossRef] [Green Version]
- Brakhage, A.A.; Schroeckh, V. Fungal Secondary Metabolites—Strategies to Activate Silent Gene Clusters. Fungal Genet. Biol. FG B 2011, 48, 15–22. [Google Scholar] [CrossRef]
- Chávez, R.; Fierro, F.; García-Rico, R.O.; Vaca, I. Filamentous Fungi from Extreme Environments as a Promising Source of Novel Bioactive Secondary Metabolites. Front. Microbiol. 2015, 6, 903. [Google Scholar] [CrossRef] [Green Version]
- Netzker, T.; Fischer, J.; Weber, J.; Mattern, D.J.; König, C.C.; Valiante, V.; Schroeckh, V.; Brakhage, A.A. Microbial Communication Leading to the Activation of Silent Fungal Secondary Metabolite Gene Clusters. Front. Microbiol. 2015, 6, 299. [Google Scholar] [CrossRef]
- Brenner, K.; You, L.; Arnold, F.H. Engineering Microbial Consortia: A New Frontier in Synthetic Biology. Trends Biotechnol. 2008, 26, 483–489. [Google Scholar] [CrossRef]
- Zuck, K.M.; Shipley, S.; Newman, D.J. Induced Production of N-Formyl Alkaloids from Aspergillus Fumigatus by Co-Culture with Streptomyces Peucetius. J. Nat. Prod. 2011, 74, 1653. [Google Scholar] [CrossRef]
- Wang, L.; Wei, W.; Tian, X.; Shi, K.; Wu, Z. Improving Bioactivities of Polyphenol Extracts from Psidium Guajava L. Leaves through Co-Fermentation of Monascus Anka Gim 3.592 and Saccharomyces Cerevisiae Gim 2.139. Ind. Crop. Prod. 2016, 94, 206–215. [Google Scholar] [CrossRef]
- Yan, P.-M.; Xue, W.-T.; Tan, S.-S.; Zhang, H.; Chang, X.-H. Effect of Inoculating Lactic Acid Bacteria Starter Cultures on the Nitrite Concentration of Fermenting Chinese Paocai. Food Control 2008, 19, 50–55. [Google Scholar] [CrossRef]
- Szambelan, K.; Nowak, J.; Czarnecki, Z. Use of Zymomonas Mobilis and Saccharomyces Cerevisiae Mixed with Kluyveromyces Fragilis for Improved Ethanol Production from Jerusalem Artichoke Tubers. Biotechnol. Lett. 2004, 26, 845–848. [Google Scholar] [CrossRef]
- Xie, X.H.; Fan, F.X.; Yuan, X.W.; Liu, N.; Liu, J.S. Isolation of High Performance Bacterial Consortium Ff and Its Decolorization Effects on Reactive Black 5. J. Donghua Univ. (Nat. Sci.) 2013, 39, 802–813. [Google Scholar]
- Meyer, V.; Stahl, U. The Influence of Co-Cultivation on Expression of the Antifungal Protein in Aspergillus Giganteus. J. Basic Microbiol. 2003, 43, 68–74. [Google Scholar] [CrossRef]
- Ola, A.; Thomy, D.; Lai, D.; Br Tz-Oesterhelt, H.; Proksch, P. Inducing Secondary Metabolite Production by the Endophytic Fungus Fusarium Tricinctum through Coculture with Bacillus Subtilis. J. Nat. Prod. 2013, 76, 2094–2099. [Google Scholar] [CrossRef] [PubMed]
- Shin, C.S.; Kim, H.J.; Kim, M.J.; Ju, J.Y. Morphological Change and Enhanced Pigment Production of Monascus When Cocultured with Saccharomyces Cerevisiae or Aspergillus Oryzae. Biotechnol. Bioeng. 2015, 59, 576–581. [Google Scholar] [CrossRef]
- Ma, Y.J.; Zheng, L.P.; Wang, J.W. Bacteria Associated with Shiraia Fruiting Bodies Influence Fungal Production of Hypocrellins A. Front. Microbiol. 2019, 10, 2023. [Google Scholar] [CrossRef]
- Jian-Feng, L.I.; Chen, L.I.; Liao, L.M. Study on Extraction of Honeysuckle Polysaccharide by Internal Boiling Method. Food Mach. 2016, 19, 155–159. [Google Scholar]
- Cubero, O.F.; Crespo, A.; Fatehi, J.; Bridge, P.D. DNA Extraction and Pcr Amplification Method Suitable for Fresh, Herbarium-Stored, Lichenized, Other Fungi. Plant Syst. Evol. 1999, 216, 243–249. [Google Scholar] [CrossRef]
- Liu, X.; Chen, Y.; Wu, L.; Wu, X.; Huang, Y. Optimization of Polysaccharides Extraction from Dictyophora Indusiata and Determination of Its Antioxidant Activity-Sciencedirect. Int. J. Biol. Macromol. 2017, 103, 175–181. [Google Scholar] [CrossRef]
- Hu, M.; Cai, Y.; Liao, X.; Hao, Z.; Liu, J. Development of an Hplc Method to Analyze and Prepare Elsinochrome C and Hypocrellins a in the Submerged Fermentation Broth of Shiria sp. Super-H168. Biomed. Chromatogr. 2012, 26, 737–742. [Google Scholar] [CrossRef] [PubMed]
- Wen, W.J.; Wu, J.Y. Effective Elicitors and Process Strategies for Enhancement of Secondary Metabolite Production in Hairy Root Cultures. Adv. Biochem. Eng. Biotechnol. 2013, 134, 55–89. [Google Scholar]
- Zhu, L.W.; Zhong, J.J.; Tang, Y.J. Significance of Fungal Elicitors on the Production of Ganoderic Acid and Ganoderma Polysaccharides by the Submerged Culture of Medicinal Mushroom Ganoderma Lucidum. Process Biochem. 2008, 43, 1359–1370. [Google Scholar] [CrossRef]
- Ishihara, A.; Nakao, T.; Mashimo, Y.; Murai, M.; Ichimaru, N.; Tanaka, C.; Nakajima, H.; Wakasa, K.; Miyagawa, H. Probing the Role of Tryptophan-Derived Secondary Metabolism in Defense Responses against Bipolaris Oryzae Infection in Rice Leaves by a Suicide Substrate of Tryptophan Decarboxylase. Phytochemistry 2011, 72, 7–13. [Google Scholar] [CrossRef] [PubMed]
- Simic, S.G.; Tusevski, O.; Maury, S.; Hano, C.; Delaunay, A.; Chabbert, B.; Lamblin, F.; Laine, E.; Joseph, C.; Hagege, D. Fungal Elicitor-Mediated Enhancement in Phenylpropanoid and Naphtodianthrone Contents of Hypericum Perforatuml. Cell Cultures. Plant Cell Tissue Organ. Cult. 2015, 122, 213–226. [Google Scholar] [CrossRef]
- Du, W.; Liang, Z.; Zou, X.; Han, Y.; Liang, J.; Yu, J.; Chen, W.; Wang, Y.; Sun, C. Effects of Microbial Elicitor on Production of Hypocrellins by Shiraia Bambusicola. Folia Microbiol. 2013, 58, 283–289. [Google Scholar] [CrossRef]
- Wang, J.W.; Zhang, Z.; Tan, R.X. Stimulation of Arteisinin Production in Artemisia Annua Hairy Roots by the Elicitor from the Endohytic Colletotrichum sp. Biotechnol. Lett. 2001, 23, 857–860. [Google Scholar] [CrossRef]
- Wakefield, J.; Hassan, H.M.; Jaspars, M.; Ebel, R.; Rateb, M.E. Dual Induction of New Microbial Secondary Metabolites by Fungal Bacterial Co-Cultivation. Front. Microbiol. 2017, 8, 1284. [Google Scholar] [CrossRef] [Green Version]
- Ma, Y.J.; Zheng, L.P.; Wang, J.W. Inducing Perylenequinone Production from a Bambusicolous Fungus Shiraia sp. S9 through Co-Culture with a Fruiting Body-Associated Bacterium Pseudomonas Fulva Sb1. Microb. Cell Factories 2019, 18, 121. [Google Scholar] [CrossRef]
- Du, W.; Sun, C.; Wang, J.; Xie, W.; Wang, B.; Liu, X.; Zhang, Y.; Fan, Y. Conditions and Regulation of Mixed Culture to Promote Shiraia Bambusicola and Phoma Sp. Bzj6 for Laccase Production. Sci. Rep. 2017, 7, 17801. [Google Scholar] [CrossRef] [PubMed]
- González-Siso, M.I.; García-Leiro, A.; Tarrío, N.; Cerdán, M.E. Sugar Metabolism, Redox Balance and Oxidative Stress Response in the Respiratory Yeast Kluyveromyces Lactis. Microb. Cell Factories 2009, 8, 46. [Google Scholar] [CrossRef] [PubMed] [Green Version]

| Strain Number | * Mycelium Biomass (g DW/L) | ** HA Content in Mycelium (mg/g Biomass) | ** HA Conversion Yield (mg/g Carbon Source) | ** HA Production (mg/L) |
|---|---|---|---|---|
| Control | 6.24 ± 0.19 | 18.99 ± 1.36 | 11.84 ± 0.65 | 118.39 ± 6.5 |
| AF-1 | 5.39 ± 1.31 | 19.79 ± 1.34 | 10.54 ± 1.85 | 114.60 ± 13.46 |
| AF-2 | 4.58 ± 0.34 | 8.12 ± 1.07 | 3.72 ± 0.54 | 37.15 ± 5.38 |
| AF-3 | 6.75 ± 1.67 | 11.85 ± 0.6 | 7.93 ± 1.57 | 79.34 ± 15.74 |
| AF-4 | 6.38 ± 0.57 | 31.69 ± 4.18 | 20.10 ± 0.88 | 201.02 ± 8.76 |
| AF-5 | 8.23 ± 0.61 | 40.5 ± 1.4 | 33.19 ± 1.31 | 332.92 ± 13.09 |
| AF-6 | 8.91 ± 0.49 | 9.6 ± 0.53 | 8.54 ± 0.04 | 85.4 ± 0.36 |
| AF-7 | 10.53 ± 0.52 | 22.92 ± 1.35 | 24.10 ± 0.23 | 240.87 ± 2.26 |
| BF-1 | 6.22 ± 0.91 | 33.17 ± 2.73 | 20.51 ± 1.3 | 205.07 ± 13.04 |
| BF-2 | 9.88 ± 1.74 | 10.72 ± 0.67 | 10.51 ± 1.25 | 105.14 ± 12.46 |
| BF-3 | 8.07 ± 0.69 | 31.29 ± 1.55 | 25.2 ± 0.92 | 251.95 ± 9.17 |
| BF-4 | 8.71 ± 1.12 | 11.71 ± 0.4 | 10.88 ± 0.36 | 108.79 ± 3.58 |
| BF-5 | 5.93 ± 0.13 | 29.25 ± 1.19 | 17.33 ± 0.33 | 173.35 ± 3.34 |
| BF-6 | 6.95 ± 0.33 | 28.11 ± 0.69 | 19.52 ± 0.91 | 195.19 ± 9.14 |
| BF-7 | 9.09 ± 0.04 | 23.45 ± 0.25 | 21.31 ± 0.32 | 213.13 ± 3.23 |
| BF-8 | 8.08 ± 0.32 | 25.43 ± 0.06 | 20.67 ± 1.06 | 206.72 ± 10.65 |
| BF-9 | 7.29 ± 0.47 | 24.11 ± 2.577 | 17.52 ± 0.75 | 175.20 ± 7.48 |
| BF-10 | 6.51 ± 0.27 | 12.89 ± 0.62 | 8.4 ± 0.73 | 85.96 ± 7.27 |
Publisher’s Note: MDPI stays neutral with regard to jurisdictional claims in published maps and institutional affiliations. |
© 2021 by the authors. Licensee MDPI, Basel, Switzerland. This article is an open access article distributed under the terms and conditions of the Creative Commons Attribution (CC BY) license (https://creativecommons.org/licenses/by/4.0/).
Share and Cite
Yan, X.; Wen, Y.; Hu, M.; Wu, Z.; Tian, X. Promotion of the Hypocrellin Yield by a Co-Culture of Shiraia bambusicola (GDMCC 60438) with Arthrinium sp. AF-5 Fungus. Fermentation 2021, 7, 316. https://doi.org/10.3390/fermentation7040316
Yan X, Wen Y, Hu M, Wu Z, Tian X. Promotion of the Hypocrellin Yield by a Co-Culture of Shiraia bambusicola (GDMCC 60438) with Arthrinium sp. AF-5 Fungus. Fermentation. 2021; 7(4):316. https://doi.org/10.3390/fermentation7040316
Chicago/Turabian StyleYan, Xiaoxiao, Yongdi Wen, Menghua Hu, Zhenqiang Wu, and Xiaofei Tian. 2021. "Promotion of the Hypocrellin Yield by a Co-Culture of Shiraia bambusicola (GDMCC 60438) with Arthrinium sp. AF-5 Fungus" Fermentation 7, no. 4: 316. https://doi.org/10.3390/fermentation7040316
APA StyleYan, X., Wen, Y., Hu, M., Wu, Z., & Tian, X. (2021). Promotion of the Hypocrellin Yield by a Co-Culture of Shiraia bambusicola (GDMCC 60438) with Arthrinium sp. AF-5 Fungus. Fermentation, 7(4), 316. https://doi.org/10.3390/fermentation7040316

